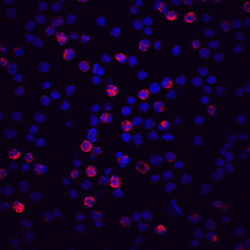

Antibody data
- Antibody Data
- Antigen structure
- References [1]
- Comments [0]
- Validations
- Western blot [1]
- Immunocytochemistry [1]
- Flow cytometry [1]
Submit
Validation data
Reference
Comment
Report error
- Product number
- MAB5980 - Provider product page

- Provider
- R&D Systems
- Product name
- Human Complement Factor H-related 4/ CFHR4 Antibody
- Antibody type
- Monoclonal
- Description
- Protein A or G purified from hybridoma culture supernatant. Detects human Complement Factor H-related 4/CFHR4 in direct ELISAs and Western blots. In direct ELISAs, no cross-reactivity with recombinant human (rh) CFHR1, rhCFHR2, or rhCFHR5 is observed.
- Reactivity
- Human
- Host
- Mouse
- Conjugate
- Unconjugated
- Antigen sequence
Q92496- Isotype
- IgG
- Antibody clone number
- 640212
- Vial size
- 100 ug
- Concentration
- LYOPH
- Storage
- Use a manual defrost freezer and avoid repeated freeze-thaw cycles. 12 months from date of receipt, -20 to -70 °C as supplied. 1 month, 2 to 8 °C under sterile conditions after reconstitution. 6 months, -20 to -70 °C under sterile conditions after reconstitution.
Submitted references Factor H-related protein 4 activates complement by serving as a platform for the assembly of alternative pathway C3 convertase via its interaction with C3b protein.
Hebecker M, Józsi M
The Journal of biological chemistry 2012 Jun 1;287(23):19528-36
The Journal of biological chemistry 2012 Jun 1;287(23):19528-36
No comments: Submit comment
Supportive validation
- Submitted by
- R&D Systems (provider)
- Main image

- Experimental details
- Detection of Human Complement Factor H-related 4/CFHR4 by Western Blot. Western blot shows lysates of human liver tissue. PVDF Membrane was probed with 2 µg/mL of Human Complement Factor H-related 4/CFHR4 Monoclonal Antibody (Catalog # MAB5980) followed by HRP-conjugated Anti-Mouse IgG Secondary Antibody (Catalog # HAF007). A specific band was detected for Complement Factor H-related 4/ CFHR4 at approximately 45 kDa (as indicated). This experiment was conducted under non-reducing conditions and using Immunoblot Buffer Group 1.
Supportive validation
- Submitted by
- R&D Systems (provider)
- Main image
- Experimental details
- Complement Factor H-related 4/CFHR4 in Human PBMCs. Complement Factor H-related 4/CFHR4 was detected in immersion fixed human peripheral blood mononuclear cells (PBMC) using Human Complement Factor H-related 4 Monoclonal Antibody (Catalog # MAB5980) at 10 µg/mL for 3 hours at room temperature. Cells were stained using the NorthernLights™ 557-conjugated Anti-Mouse IgG Secondary Antibody (red; Catalog # NL007) and counterstained with DAPI (blue). Specific staining was localized to cytoplasm. View our protocol for Fluorescent ICC Staining of Cells on Coverslips.
Supportive validation
- Submitted by
- R&D Systems (provider)
- Main image

- Experimental details
- Detection of Complement Factor H-related 4/CFHR4 in HepG2 Human Cell Line by Flow Cytometry. HepG2 human hepatocellular carcinoma cell line was stained with Human Complement Factor H-related 4/CFHR4 Monoclonal Antibody (Catalog # MAB5980, filled histogram) or isotype control antibody (Catalog # MAB002, open histogram), followed by Allophycocyanin-conjugated Anti-Mouse IgG F(ab')2 Secondary Antibody (Catalog # F0101B). To facilitate intracellular staining, cells were fixed with PFA and permeabilized with saponin.